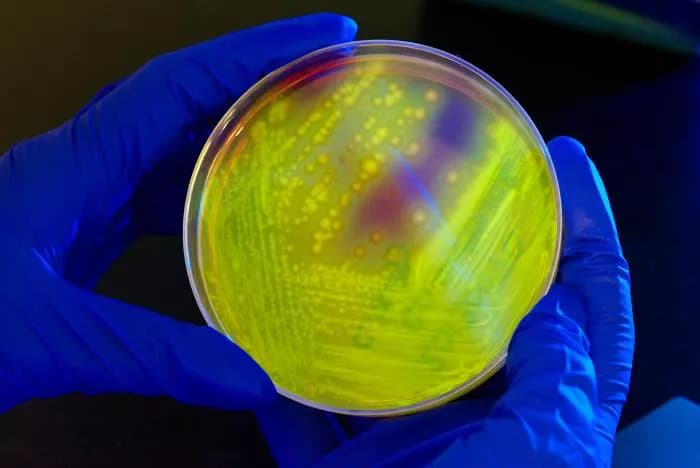
CDC/James Gathany

Hospital Disinfectants Struggling To Kill C. Diff Bacteria Colonies
The deadly and notoriously stubborn superbug, Clostridioides difficile (C. diff), is putting up a winning fight against hospital-grade disinfectants meant to kill it, according to results of a new study published in the Antimicrobial Agents and Chemotherapy journal of the American Society for Microbiology. The C. diff bacterium causes inflammation of the colon with symptoms ranging from diarrhea to life-threatening sepsis and is most common among the elderly in hospitals or other health care facilities.
"We found no disinfectant was able to completely eliminate C. difficile embedded within biofilms, although we did note differences among disinfectants," reports Kevin Garey, professor of pharmacy practice at the University of Houston and chair of the College of Pharmacy Department of Pharmacy Practice and Translational Research. Garey was the project's principal investigator. The paper was the doctoral thesis of first author, Tasnuva Rashid, of the University of Texas School of Public Health.
Overall, Clorox, Cidex OPA, and Virex were most effective at killing C. diff spores. Clorox and OPA were also effective at killing total vegetative cell growth, the cellular stage responsible for causing infections. Virex was found to be ineffective against vegetative cell growth in biofilms. Clorox and Virex were most effective in reducing biomass followed by Nixall, Cidex OPA and Vital oxide.
No previous studies have investigated chemical disinfection of C. diff spores embedded in biofilms. For the project, five unique C. diff strains, embedded in three different biofilm types grown for 72 or 120 hours, were exposed to seven different hospital disinfectants.
Bacteria can grow on almost any surface and forms a complex biofilm, like a "suit of armor," as Garey described it, where it can survive and thrive -- think of slime inside an old garden hose or plaque on your teeth -- biofilms both. More devastating biofilms form on medical devices like catheters or injection ports, giving bacteria direct access to a patient.
In the center of a biofilm, a spot exists without oxygen, an attractive locale for the anaerobic C. diff spore, which dies when it touches oxygen. Rashid was able to get a spore to germinate and replicate itself within a biofilm while exposed to an oxygen-rich environment.
"This study helps explain why C. diff is so hard to eradicate from the environment and demonstrates the ability of these spores to be so omnipresent and self-propagate in the environment," said Garey.
The survival of C. diff in hospitals and nursing homes is especially hazardous. The Centers for Disease Control and Prevention report that within a month of diagnosis, one in 11 people over age 65 died of a health care-associated C. diff infection. Garey reports that approximately 1% of all people over age 80, whether sick or not, will die of a C. diff infection.
Garey said future research could include improving existing cleansers. "Clorox is the best we have but is still quite caustic to the environment. There is likely a future where we could improve upon it to make an even more superior disinfectant to fight deadly superbugs."
Related Articles
Test Your Knowledge
Asked by users
Related Centers
Related Specialties
Related Physicians
Related Procedures
Related Resources
Join DoveHubs
and connect with fellow professionals

0 Comments
Please log in to post a comment.